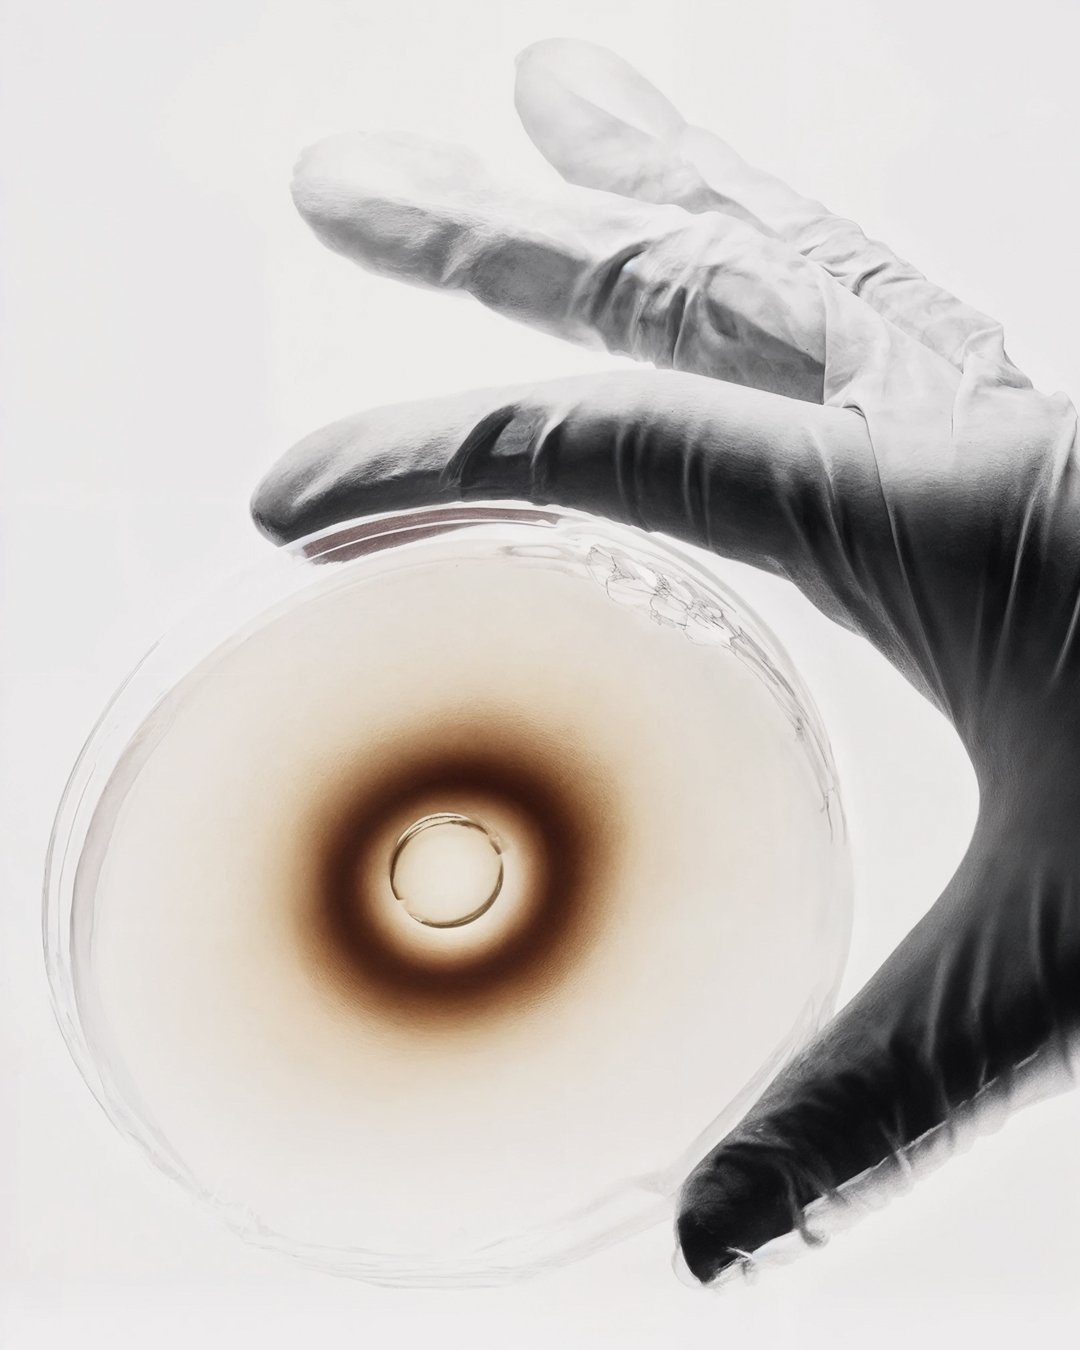

RETO
Myceutical nace como una plataforma de cosmecéutica que permite a emprendedores lanzar su propia marca de skincare a partir de formulaciones naturales listas para comercializar. El reto consistía en construir un sistema visual modular y neutro capaz de expresar tecnología y accesibilidad a la vez que deja espacio para que otras marcas puedan tener su propio carácter y expresión.
SOLUCIÓN
Desarrollamos una estrategia y un sistema visual basados en dos pilares: la célula, como key visual que sintetiza el origen científico de las formulaciones y aporta un lenguaje flexible y riguroso; y el lienzo en blanco, un recurso conceptual que representa el espacio desde el cual cada emprendedor puede construir su propia marca. El resultado es una identidad modular y habilitadora que permiten que Myceutical actúe como plataforma para terceros: clara, accesible y lista para escalar nuevos lanzamientos.
IMPACTO
Myceutical nace como una plataforma de cosmecéutica que permite a emprendedores lanzar su propia marca de skincare a partir de formulaciones naturales listas para comercializar. El reto consistía en construir un sistema visual modular y neutro capaz de expresar tecnología y accesibilidad a la vez que deja espacio para que otras marcas puedan tener su propio carácter y expresión.
SOLUCIÓN
Desarrollamos una estrategia y un sistema visual basados en dos pilares: la célula, como key visual que sintetiza el origen científico de las formulaciones y aporta un lenguaje flexible y riguroso; y el lienzo en blanco, un recurso conceptual que representa el espacio desde el cual cada emprendedor puede construir su propia marca. El resultado es una identidad modular y habilitadora que permiten que Myceutical actúe como plataforma para terceros: clara, accesible y lista para escalar nuevos lanzamientos.
IMPACTO
︎ Posicionamiento diferenciador dentro de la categoría de cuidado oral.
︎ 38% de aumento en solicitudes de cita tras el lanzamiento.
︎ 25% de incremento en bundles y ventas cruzadas vinculadas a joyería dental.
SERVICIOS
Desarrollado en Casa Bien
Consultoría
Estrategia de marca
Identidad visual
Dirección de arte
Diseño gráfico
Diseño web
Aplicaciones
Desarrollado en Casa Bien
Consultoría
Estrategia de marca
Identidad visual
Dirección de arte
Diseño gráfico
Diseño web
Aplicaciones

Dirección creativa: Andrea Arqués
Dirección estratégica: Alberto García
Dirección de arte y diseño gráfico: Andrea Arqués
Identidad verbal: Antton Alonso